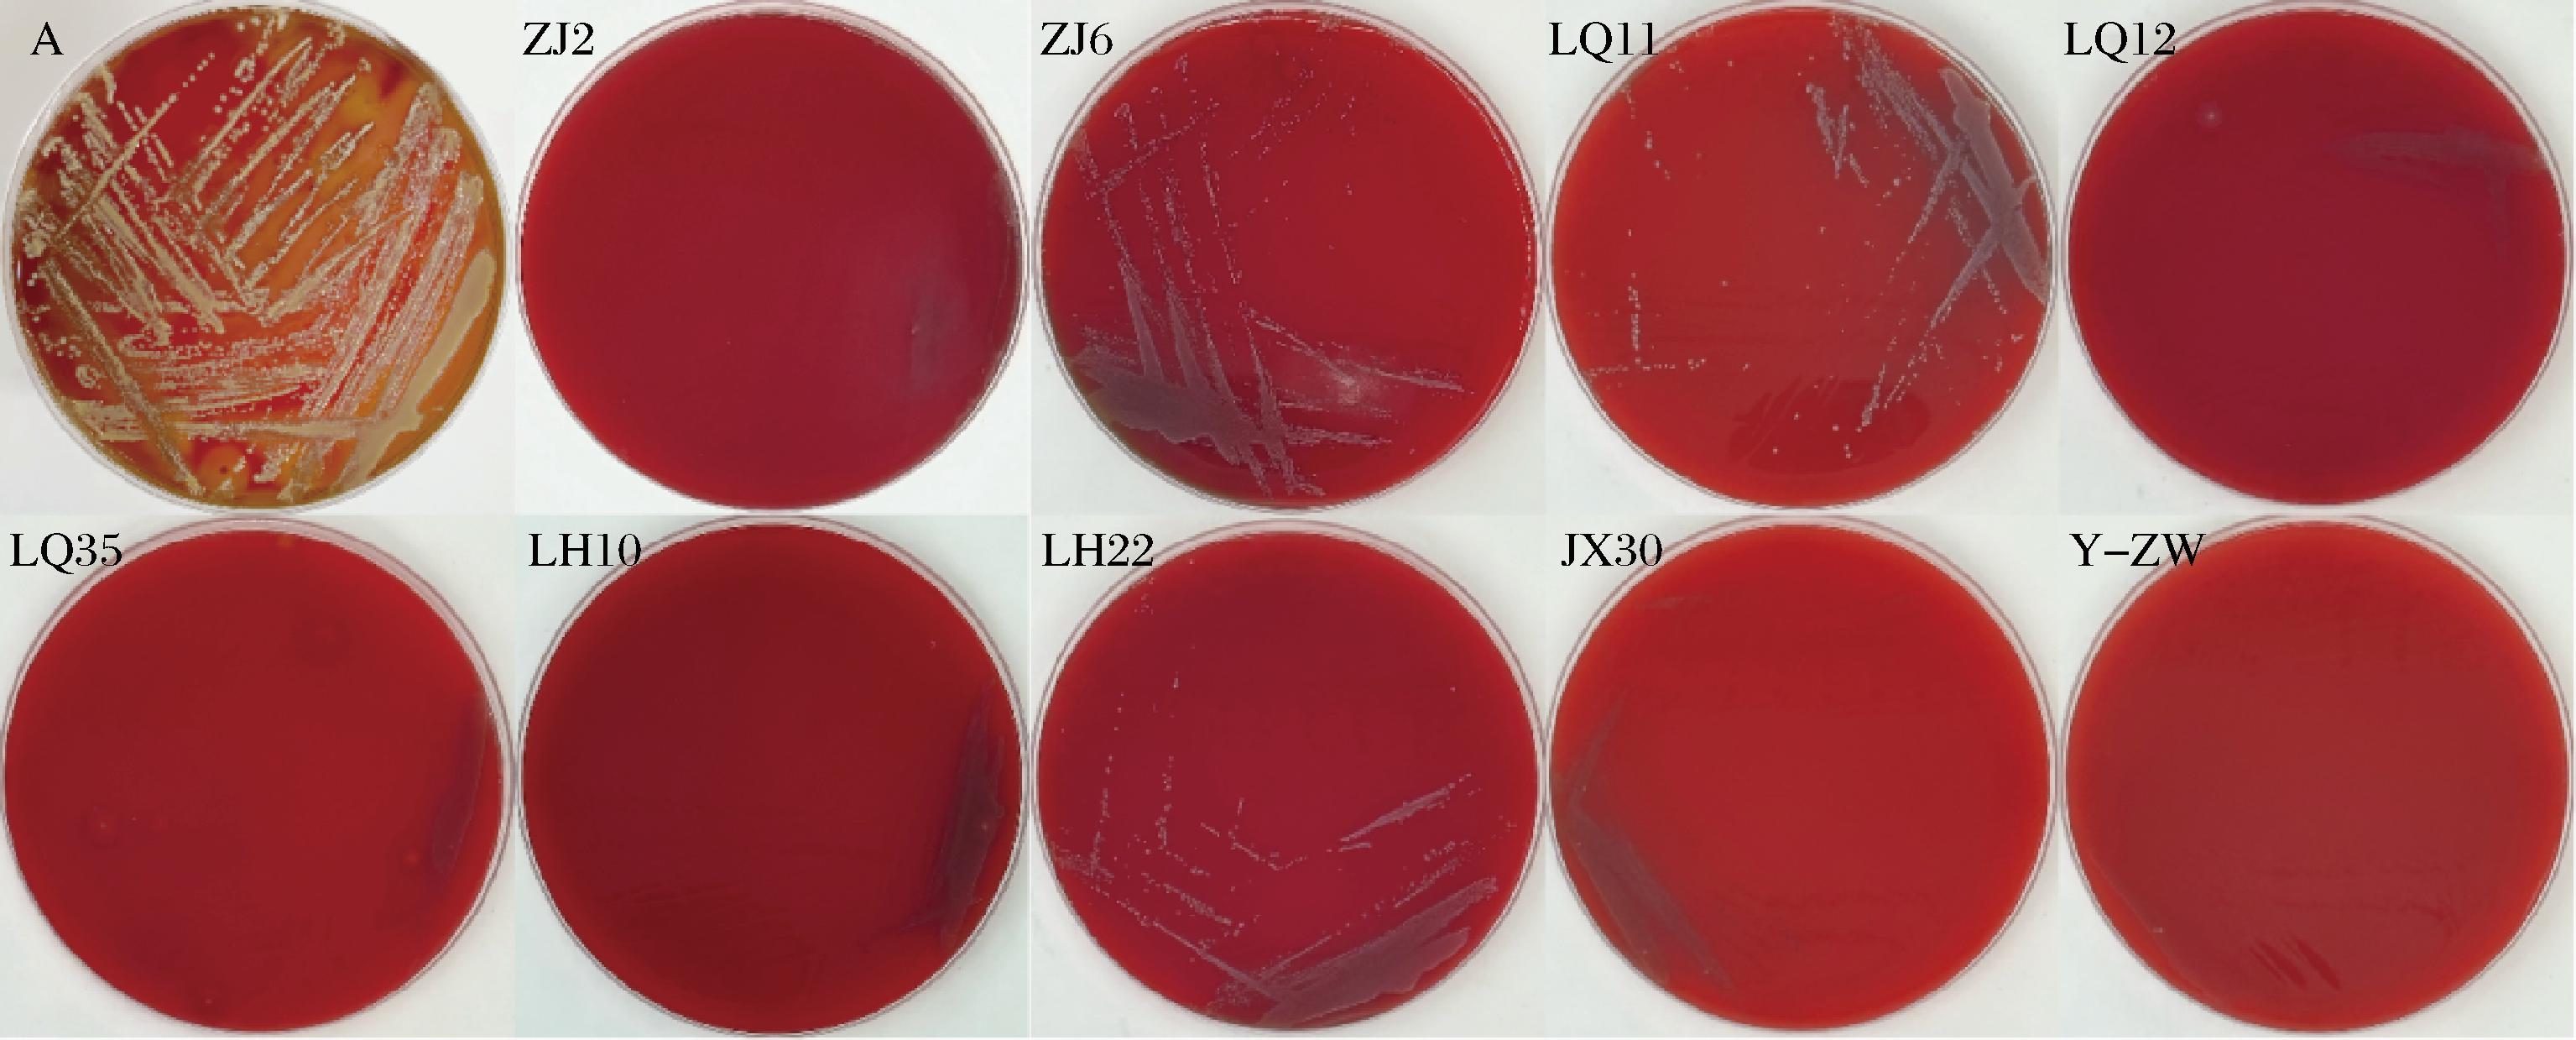

乳酸菌作为重要的工业微生物,在食品发酵、营养强化及功能活性物质合成中发挥着关键作用。其通过代谢产物(如有机酸、细菌素及胞外多糖)不仅可改善食品风味与质地,还能显著提升制品的抗氧化、降胆固醇等健康功能[1]。近年来,乳酸菌的应用基质已从传统乳制品拓展至谷物、果蔬等植物基原料。KARAYE等[2]从酿制饮料、某些腐烂水果、猪盲肠等筛选的乳酸菌对多种谷物进行发酵,发现其发酵小麦底物时pH降至4.1以下,并同步提升了游离氨基酸的总量,表明筛选的菌株可有效改善谷物基质的理化特性与功能价值。小麦胚芽因其富含天然抗氧化成分以及高营养价值(蛋白质含量25%~30%、维生素E 150~300 mg/100 g)备受关注[3]。然而,小麦胚芽中高脂质含量(10%~15%)易引发脂质氧化,导致品质劣变,限制其在食品工业中的应用。针对这一挑战,有研究者尝试通过乳酸菌发酵技术提升小麦胚芽的稳定性与功能特性。KHOSROSHAHI等[4]发现,混合接种植物乳植杆菌与嗜酸乳杆菌可使20%(质量分数)小麦胚芽溶液的抗氧化活性从51.18%提升至89.76%,脂氧合酶活性抑制率达73.2%。尽管如此,现有研究多聚焦于菌株的抗氧化代谢调控,而针对蛋白酶活性菌株的系统筛选及其通过酶解小麦胚芽蛋白释放功能肽,进一步提升其抗氧化活性的机制仍待进一步探索。本研究从不同地区传统腌制蔬菜中,定向筛选高产蛋白酶的乳酸菌株,结合耐药性、环境耐受性、发酵特性以及抗氧化活性分析,系统评估菌株对小麦胚芽抗氧化性能的调控作用。研究结果将为功能性谷物发酵制品的开发提供数据支持与菌种资源。
1 材料与方法
1.1 材料与仪器
1.1.1 材料
传统腌制蔬菜样品:分别采集于贵州、江西、河南、安徽、江苏等9个不同地区的家庭自制腌制蔬菜。样品采集均由研究团队成员亲自执行,通过无菌工具进行采集50 g样品,并放入无菌袋中-20 ℃下保存,直至后续实验使用。
1.1.2 试剂
DPPH、ABTS、氯化三苯四氮唑(TPTZ),美国Sigma公司;1492R、27F引物,生工生物工程(上海)股份有限公司;MRS培养基,杭州百思生物技术有限公司;BCA试剂盒,美国Thermo Fisher公司。
1.1.3 仪器与设备
SW-CJ-2F双人操作超净工作台,苏州市净化设备有限公司;ABI2070型PCR仪,美国Applied Biosystems公司;LDZX-50KBS立式高压蒸汽灭菌锅,上海三发科学仪器有限公司;MINI-300电泳仪,美国Major science公司。
1.2 实验方法
1.2.1 菌株的分离纯化
将先前保存于-20 ℃下的腌制蔬菜在无菌条件下研磨出汁,取1 mL蔬菜汁放入9 mL无菌生理盐水(8.5 g/L NaCl)中,按体积1∶10进行梯度稀释。于含10 g/L CaCO3的MRS固体培养基中涂布,37 ℃环境下培养48 h,挑选有明显CaCO3溶解能力且菌落形态不同的菌株进行划线分离,分离3~5代,直至得到纯的培养物[5]。分离出的菌株通过革兰氏染色和过氧化物酶测试进行初步鉴定。将革兰氏染色阳性和过氧化物酶阴性的纯培养物保存在-80 ℃下,并加入体积分数30%的甘油进行保存。
1.2.2 产蛋白酶分离株的筛选
初筛采用琼脂扩散法[6]评估菌株产蛋白酶能力,将活化菌液(100 μL)接种于MRS肉汤(10 mL),30 ℃培养12 h制备菌悬液,以含10 g/L酪蛋白的MRS琼脂为筛选基质,无菌打孔器制备直径10.00 mm孔穴,每孔注入菌悬液200 μL,30 ℃培养72 h后测定蛋白水解圈直径(含孔径)。初筛标准为水解圈直径(水解圈直径≥15.00 mm,含孔径10.00 mm)。
复筛是通过Folin-Ciocalteu法[6]测定蛋白酶活性,取菌株发酵上清液1.0 mL,与1%酪蛋白溶液(1.0 mL)于40 ℃反应10 min,加入20%三氯乙酸终止反应,离心(8 000×g,10 min)后取上清液1.0 mL,依次加入0.55 mol/L Na2CO3(5.0 mL)和Folin-Ciocalteu试剂(1.0 mL),40 ℃显色20 min后测定680 nm波长处吸光度。以酪氨酸标准曲线计算酶活性(1 U定义为40 ℃,1 min催化生成1 μg酪氨酸当量),最终筛选标准为水解圈直径≥15.00 mm且蛋白酶活性≥20.00 U/mL。
1.2.3 分离株的鉴定
参考QB/T 5165—2017《食品用乳酸菌鉴定技术指南》对分离株进行生理、生化初步鉴定;参考MA等[6]的方法对分离株进行16S rDNA测序,将得到的序列与美国国家生物技术信息中心(National Center for Biotechnology Information, NCBI)数据库的基本局部比对搜索工具(Basic Local Alignment Search Tool, BLAST)进行比对,并使用软件MEGA12制作系统发育树。
1.2.4 分离株生长性能分析
将100 μL菌悬液接种于200 mL的无菌MRS液体培养基中,置于37 ℃、180 r/min培养24 h,每隔2 h测定发酵液OD600值与pH值,每次设置3个重复,绘制生长曲线及产酸曲线[7]。
1.2.5 分离株环境耐受性分析
为了研究温度对分离株的影响,将分离株在30 ℃ 的MRS中培养24 h,将每种细菌悬浮液100 μL加入10 mL MRS肉汤中,在不同温度(20、30、40、50、60、70、80 ℃)下水浴15 min,37 ℃环境下培养24 h,通过测量OD600来评估生长情况[7]。为了检测分离株对不同pH值的耐受性,将100 μL按上述方法制备的细菌悬浮液加入10 mL MRS肉汤中,用NaOH(0.5 mol/L)和HCl(0.5 mol/L)溶液调节至不同的pH值(4.0~10.0,每隔1.0设1个梯度),然后在37 ℃下培养24 h[7]。为了检测分离株对渗透压的抗性,将菌株重悬于添加了NaCl(30、40、50、60 g/L)的MRS肉汤中。在含有4 g/L胆盐的MRS肉汤中加入细菌溶液并在37 ℃下培养4 h,以测定胆盐耐受性,不含胆盐的MRS肉汤用作对照[6]。
1.2.6 分离株安全性评价
1.2.6.1 溶血性试验
将活化后的分离株划线接种于哥伦比亚血琼脂培养基中,以金黄色葡萄球菌为阳性对照菌株,观察菌株的溶血情况。α-溶血表现为菌落周围呈现草绿色溶血环,表示不完全溶血;β-溶血是溶血环界限清晰且完全透明,意味着红细胞完全溶血;γ-溶血是菌落周围无溶血现象,即不溶血[7]。
1.2.6.3 抗生素敏感性分析
采用纸片扩散法[8](Kirby-Bauer法)评估菌株对6种抗生素(四环素、氯霉素、庆大霉素、左氧氟沙星、复方新诺明、青霉素)的耐药表型。将菌悬液均匀涂布于MRS琼脂平板,固定抗生素纸片后于37 ℃培养24 h,依据抑菌圈直径判定敏感性(敏感、中度敏感或耐药)。植物乳植杆菌(Lactiplantibacillus plantarum)判定标准依据CLSI M45-2016《抗菌药物稀释和纸片法敏感性测试方法》及欧洲食品安全局(European Food Safety Authority, EFSA)指南;肠膜明串珠菌(Leuconostoc mesenteroides)判定标准参照CLSI M100 ED33-2023《抗微生物药物敏感性试验执行标准》。
1.2.7 分离株耐药基因检测
参考文献[7,9-11],根据6种抗生素选择了10种耐药基因,具体引物序列信息如表1所示。以每株菌株的DNA为模板,进行PCR扩增。PCR反应体系包括2 μL模板DNA、1 μL上游引物(10 μmol/L)、1 μL下游引物(10 μmol/L)、12.5 μL 2×Taq Plus Master Mix以及8.5 μL Ldd H2O,总体积为25 μL。PCR反应条件为:预变性在95 ℃下进行600 s,接着在95 ℃下进行30 s的变性,退火温度根据引物的不同按表1设定,退火时间40 s,延伸温度72 ℃,延伸时间30 s,最后72 ℃下进行600 s的终延伸。
表1 十种耐药基因PCR引物序列
Table 1 PCR primer sequences for 10 drug resistance genes

药物种类目的基因引物序列产物大小/bp退火温度/℃来源四环素类tet(M)tet(C)F-TTATCTGTATCACCGCTTCCR-CAGTCCGTCACATTCCAACCF-TCTAACAATGCGCTCATCGTR-GGTTGAAGGCTCTCAAGGGC65757[9]56953[9]氯霉素类catF-TTAGGTTATTGGGATAAGTTAR-GCATGRTAACCATCACAWAC30048[7]氨基糖苷类ant(6)F-ACTGGCTTAATCAATTTGGGR-GCCTTTCCGCCACCTCACCG59758[10]喹诺酮类qnrAqnrBF-ATTTCTCACGCCAGGATTTGR-GATCGGCAAAGTTAGGTCAF-ACGATGCCTGGTAGTTGTCCR-GATCGTGAAAGCCAGAAAGG51653[11]46954[9]磺胺类sulⅠsulⅡF-TCACCGAGGACTCCTTCTTCR-CAGTCCGCCTCAGCAATATCF-CCTGTTTCGTCCGACACAGAR-GAAGCGCAGCCGCAATTCAT33154[9]43554[9]β-内酰胺类blaTEMblaF-CAGAAACGCTGGTGAAAGTAR-ACTCCCCGTCGTGTAGATAAF-CATARTTCCGATAATASMGCCR-CGTSTTTAACTAAGTATSGY71954[9]29751[9]
1.2.8 分离株发酵小麦胚芽的特性分析
1.2.8.1 脱脂小麦胚芽浆(skimmed wheat germ pulp,SWGP)制作工艺
使用5倍量的正己烷对新鲜无杂质的小麦胚芽进行脱脂处理,去除脂肪成分;并通过抽滤去除溶剂,将脱脂后的小麦胚芽均匀平铺在托盘中,置于鼓风干燥箱内37 ℃低温烘干,放入干燥器中备用[12]。将脱脂的小麦胚芽与水按料液比1∶20(g∶mL)混合,煮至沸腾后,通过破壁机高速研磨2 min后得到SWGP,将处理后的SWGP按料液比1∶10(g∶mL)与水混合后进行分装,分装好的小麦胚芽浆105 ℃高压灭菌15 min后,将乳酸菌发酵液以4%的接种量接种于SWGP进行发酵,37 ℃培养36 h后,对发酵前后的SWGP进行理化性质分析。
1.2.8.2 不同分离株发酵SWGP理化性质分析
采用平板计数法测定发酵液总活菌数(total viable count, TVC):将样品梯度稀释后涂布于MRS琼脂,37 ℃培养48 h后计数菌落数(稀释梯度10-6~10-4)[13];pH值测定依据GB 5009.237—2016《食品安全国家标准 食品pH值的测定》;总酸的测定参照GB 12456—2021《食品安全国家标准 食品中总酸的测定(含第1号修改单)》进行酸碱滴定;蛋白质含量采用BCA法定量分析,将样本经12 000 r/min离心15 min后取上清液,按试剂盒说明配制50∶1的BCA工作液,与样品混匀后37 ℃孵育30 min,冷却后于562 nm测定吸光度,并根据标准曲线计算浓度。
1.2.8.3 不同分离株发酵对SWGP抗氧化活性的影响
以DPPH、ABTS阳离子、羟自由基(·OH)清除率及铁离子还原反应(ferric ion reducing antioxidant power, FRAP)[14]为指标分别探究SWGP发酵前与不同分离株发酵后的体外抗氧化能力,选用SWGP发酵后体外抗氧化活性最优的菌株进一步分析。
1.3 数据统计与分析
使用Excel 2021、SPSS 26软件进行数据处理与分析,使用Origin 2022、MEGA12、GraphPad Prism10进行作图;所有数据以“平均值±标准差”的形式表示。
2 结果与分析
2.1 菌株的分离纯化
基于腌制蔬菜作为天然乳酸菌富集培养基的特性(低氧、高盐环境及菌群多样性特征),采用选择性培养基对不同地区家庭自制腌菜样本进行菌株分离。通过钙溶圈筛选法及形态学鉴定(革兰氏阳性、过氧化氢酶阴性),共分离获得680株候选菌株,其菌落特征为圆形或椭圆形、微白色、具光泽的典型乳酸菌表型。分离株经纯化后保存于-80 ℃甘油管保藏体系。
2.2 产蛋白酶分离菌株的筛选
采用琼脂扩散法进行初筛,从680株分离株中筛选获得32株具有明显蛋白水解活性的候选菌株。之后通过Folin-Ciocalteu比色法进行复筛,进一步筛选出9株蛋白酶活性>20.00 U/mL的高效菌株。根据表2的结果,菌株LH22表现出最佳的蛋白水解性能,其水解圈直径为(25.51±0.32) mm,蛋白酶活性为(33.93±0.85) U/mL,显著优于其他菌株。虽然菌株LQ12在酪蛋白水解方面表现最佳(38.19±0.17) mm,但其蛋白酶活性仅为20.07 U/mL,显示水解圈的大小与酶活性之间存在负相关性。这可能是因为某些菌株在培养初期产酶较快且扩散迅速,短时间内形成较大的水解圈,随着这些菌株的液体培养中产酶总量较低,或酶易失活,导致最终测得的蛋白酶活性较低;此现象与MA等[6]的研究结果一致,水解圈的大小并不一定与蛋白酶活性呈正相关。
表2 蛋白酶菌株的初筛和复筛(n=3)
Table 2 Initial and rescreening of protease strains(n=3)

分离源 菌株编号蛋白水解圈直径/mm蛋白酶活性/(U/mL)江西宜春(JX)JX3015.93±0.25g21.51±0.32h安徽临泉(LQ)LQ1115.39±0.15h25.22±0.14dLQ1238.19±0.17a20.07±0.25iLQ3521.32±0.16e25.76±0.42cLH1016.35±0.18f21.83±0.24gLH2225.51±0.23b33.93±0.25a江苏镇江(ZJ)ZJ224.31±0.21c22.18±0.15fZJ622.51±0.18d22.39±0.32e实验室自留Y-ZW22.35±0.21d26.14±0.05b
注:小写字母表示同列不同种类间的显著性差异(P<0.05)(下同)。
2.3 分离株鉴定
2.3.1 生理生化鉴定
生理生化鉴定结果显示(表3),所有菌株的过氧化氢酶试验与明胶液化试验均为阴性,均能代谢蔗糖、葡萄糖、麦芽糖,表明其具备典型的乳酸菌糖酵解途径及磷酸转酮酶活性,符合乳酸菌的典型特征。菌株ZJ2、ZJ6、LQ12、LQ35、Y-ZW在碳水化合物利用试验中通常无法代谢L-阿拉伯糖,与张平等[15]的研究结果一致,初步判断为L. plantarum;而菌株LQ11、LH10、LH22、JX30的L-阿拉伯糖代谢阳性特征与L. mesenteroides的代谢特性高度吻合。
表3 菌株的生理生化鉴定结果
Table 3 Physiological and biochemical characterisation of the strain

实验菌株编号ZJ2ZJ6LQ11LQ12LQ35LH10LH22JX30Y-ZW过氧化氢酶试验---------明胶液化试验---------蔗糖 +++++++++葡萄糖 +++++++++麦芽糖 +++++++++L-阿拉伯糖--+--+++-
注:“+”代表阳性;“-”代表阴性(表4同)。
2.3.2 分子生物学鉴定
基于生理生化鉴定与16S rDNA系统发育分析(图1),9株分离株可分为两类:L. plantarum(ZJ2、ZJ6、LQ12、LQ35、Y-ZW)及L. mesenteroides(LQ11、LH10、LH22、JX30),该结果与生理生化鉴定结果一致。

图1 基于16S rDNA基因序列构建的系统发育树
Fig.1 Phylogenetic tree constructed on the basis of 16S rDNA gene sequences
2.4 分离株生长曲线与产酸曲线
如图2所示,9株分离株的生长曲线及产酸特性呈现显著差异。在0~3 h的迟缓期内菌体增殖较为缓慢,OD600值无显著变化(初始均值0.35±0.02),pH从6.0降至5.3左右,降幅约为0.7。进入对数生长期(3~9 h)后,菌株Y-ZW与LQ35表现出显著的生长优势,Y-ZW的OD600从0.384增至1.927,pH值由5.43降至4.08,LQ35的OD600从0.383升至1.875,pH值由5.47降至4.07,产酸速率分别为0.23 h-1和0.21 h-1,显著高于其他菌株。稳定期(10~20 h)OD600到达峰值,pH值维持在3.8~4.2区间。20 h后的衰亡期菌的生长开始下降,产酸停滞,如ZJ2的pH值仅降低0.24。

a-生长曲线;b-产酸曲线
图2 分离株生长曲线及产酸曲线
Fig.2 Growth curve and acid production curve of isolates

a-生长温度;b-生长pH;c-NaCl浓度;d-胆盐
图3 分离株环境耐受性
Fig.3 Environmental tolerance of isolated strains
菌种生长特性分析表明,植物乳植杆菌属菌株(ZJ2、ZJ6、LQ12、LQ35、Y-ZW)具有更优的发酵适应性,其对数期启动时间较肠膜明串珠菌属(LQ11、LH10、LH22、JX30)提前2~3 h,且生长性能显著高于后者。产酸动力学显示,植物乳植杆菌在3~8 h内pH值降幅达1.35~1.40,而肠膜明串珠菌仅0.8~1.0。值得注意的是,肠膜明串珠菌在衰亡期表现出pH稳定性,表明其代谢产物可能在发酵后期维持体系稳态。
2.5 分离株环境耐受性测定
通过对9株乳酸菌的环境耐受性进行分析,研究了它们在不同应激条件下的生存能力。如图3-a所示,LH22菌株在60 ℃高温下的存活率达到了80%,显著高于嗜酸乳杆菌CICC6074(其在50 ℃下的存活率为45%),这一差异可能与热激蛋白HSP60的高表达有关[16]。如图3-b所示,在pH 5~10的环境下菌株具有较好的适应能力,在酸性环境(pH 5~6)中表现出较强的耐酸性。菌株对酸性环境的耐受性较差,而对碱性环境的耐受性则较强,在pH值接近4时,细菌存活率接近于零,在pH值为5时的存活率稍有提升;当pH值升高至7以上时,部分菌株的存活率表现出明显提高,尤其是在pH值为8和9时,菌株LH22显示出较强的耐碱性,存活率接近100%,在pH 10.0的强碱性环境中,LH22、LQ11和ZJ6菌株的存活率均超过90%。耐盐性实验显示(图3-c),所有菌株在50 g/L NaCl下均能正常生长,而ZJ6、LQ12、LQ35和Y-ZW菌株在50 g/L NaCl的高渗条件下存活率仍超过80%,显著优于植物乳植杆菌K25(在50 g/L NaCl条件下的抑制率为70%)。此外,ZJ6和LH22在4 g/L胆盐胁迫下的存活率超过60%(图3-d),表现出更强的肠道定植潜力,相比之下,L. reuteri ATCC 55739在0.3%胆盐中的存活率为50%[17]。值得注意的是,菌株ZJ6、LQ11和LH22不仅具备极强的耐碱性(pH=10.0时存活率为91.5%),还表现出较高的胆盐耐受性,适合用于开发功能性益生菌制剂。
2.6 溶血性鉴定
基于哥伦比亚血琼脂培养基的溶血性测试结果显示,阳性对照菌金黄色葡萄球菌呈现典型的β-溶血(透明溶血环),而本研究的9株分离株均表现为α-溶血(草绿色溶血环),未观察到β-溶血现象,具有较好的安全性(图4)。这一结果符合李斯淼等[7]对乳酸菌安全性的评价标准,即α-溶血菌株仍符合食品安全要求,且未表现出溶血素相关毒力基因表达。
图4 分离株溶血试验结果
Fig.4 Results of haemolysis test of isolates
2.7 抗生素敏感性及耐药基因分析
虽然当前研究多聚焦于致病菌的耐药机制,但对益生菌的耐药性评估同样至关重要,直接关系到益生菌的安全性。如图5所示,9株菌在对六类抗生素的敏感性测试中表现出不同的耐药性,所有菌株对氟喹诺酮类(左氧氟沙星)耐药,表明这些乳酸菌可能具有一定的天然耐药性或通过某些机制获得了耐药性;8/9菌株对氨基糖苷类(庆大霉素)耐药(LQ35敏感);菌株LQ11对四环素耐药,LQ12对青霉素耐药。抗生素的耐药性可能会影响到肠道微生态的平衡以及人体健康的安全性,因此在益生菌的开发和应用过程中,应特别关注其对常用抗生素的耐药性。

图5 分离株的抗生素敏感性
Fig.5 Antibiotic susceptibility of isolates

图6 分离株发酵SWGP的抗氧化能力
Fig.6 Antioxidant capacity of isolated strains of fermented SWGP
有关研究表明,乳酸菌可能通过自然选择进化、携带耐药基因、主动外排泵系统或菌株间基因转移等方式产生耐药性[18]。本研究通过多重PCR检测9株乳酸菌携带的10类抗生素耐药基因(表4),发现其耐药表型与基因型呈现显著关联性。ZJ2携带β-内酰胺类耐药基因blaTEM,符合乳杆菌属中质粒介导的获得性耐药特征;ZJ6对磺胺类药物(sulⅠ/sulⅡ阳性)的耐药性与可移动遗传元件携带的耐药基因转移相关。LQ11和LH22分别检出qnrB(喹诺酮类)、tet(C)/tet(M)(四环素类)及sulⅡ(磺胺类)等多重耐药基因,其广谱耐药表型(耐药基因数≥3)与内蒙古传统发酵乳制品中乳酸菌的多重耐药特性高度相似。值得注意的是,LQ11的qnrB基因通过保护DNA旋转酶靶点介导环丙沙星耐药,该机制与致病菌中喹诺酮耐药基因功能保守性一致。
表4 分离株的抗生素耐药基因检测
Table 4 Detection of antibiotic resistance genes in isolates

抗生素分类耐药基因菌株编号ZJ2ZJ6LQ11LQ12LQ35LH10LH22JX30Y-ZW四环素类tet(M)------+--tet(C)-----+---氯霉素类cat--+--+++-氨基糖苷类ant(6)---------喹诺酮类qnrA---------qnrB--+---+--磺胺类sulⅠ-+-------sulⅡ-++--+++-β-内酰胺类blaTEM+--------bla---------
耐药表型与基因型关联存在四类典型模式:①基因型-表型一致性:qnrB介导的喹诺酮类耐药(LQ11/LH22)及blaTEM介导的β-内酰胺类耐药(ZJ2),符合基因型驱动表型理论。②表型耐药-基因型阴性:8株菌对庆大霉素耐药但未检出氨基糖苷修饰酶基因,可能源于外排泵激活或未检测的新型耐药机制。③基因型阳性-表型敏感:ZJ6(sulⅠ/sulⅡ阳性)对磺胺类药物敏感,可能是因耐药基因沉默或表达抑制。④双阴性关联:LQ12/LQ35/Y-ZW无耐药基因且表型敏感,可能由于这些菌株天然不携带相关耐药基因,或抗性通过非基因依赖机制获得,符合EFSA推荐的食品级乳酸菌安全标准。
2.8 分离株发酵SWGP理化性质分析
由表5可知,乳酸菌发酵SWGP后,各菌株的活菌数均超过7.50 lg CFU/mL以上,其中Y-ZW菌株的活菌数最高,达到了(8.10±0.13) lg CFU/mL。未发酵的SWGP基料初始pH值为7.17±0.00,经乳酸菌发酵后,各组的pH值均显著降低至3.80~4.25,表明在发酵过程中大量有机酸(如乳酸)得到了积累。总酸含量也因微生物代谢作用而显著增加,其中ZJ6菌株发酵后的总酸含量最高,为(9.60±0.40) g/kg,是未发酵组(1.47±0.23) g/kg的6.5倍,其次是Y-ZW(9.47±1.22) g/kg和LQ12 (9.20±0.80) g/kg。
表5 分离株发酵SWGP的理化特性
Table 5 Physicochemical properties of SWGP fermented by isolates

分离株活菌数/(lg CFU/mL)pH值总酸/(g/kg)蛋白质/(μg/mL)ZJ28.05±0.07ab3.83±0.01d7.73±0.23b741.31±2.73bcdZJ68.06±0.14ab3.82±0.01d9.60±0.40a738.95±4.83bcdLQ117.90±0.10bc4.13±0.04c6.40±0.40c771.29±3.05bcLQ128.08±0.03a3.83±0.01d9.20±0.80a719.81±4.32cdLQ357.99±0.15ab3.82±0.00d8.40±0.80ab724.80±2.28cdLH108.05±0.03ab3.85±0.01d8.40±0.00ab790.19±6.64bLH228.03±0.05ab4.25±0.07b4.67±0.61d589.94±1.87dJX307.79±0.04c4.25±0.01b4.67±0.46d554.87±4.17dY-ZW8.10±0.13a3.83±0.00d9.47±1.22a744.28±3.00bcd未发酵0.00±0.00d7.17±0.00a1.47±0.23e906.91±2.85a
此外,虽然LH22和JX30菌株的总酸含量较低[(4.67±0.61) g/kg],但仍显著高于未发酵组。发酵后,各组的蛋白质含量整体呈下降趋势,JX30菌株的蛋白质下降幅度最大,达到了38.8%。这与ZHANG等[19]关于茶蛋白发酵过程中水溶性蛋白降解及活性肽释放的研究结果一致,即乳酸菌厌氧发酵中,蛋白酶有助于将蛋白质分解为更易被吸收的氨基酸和肽,这可能与本研究中菌株蛋白酶活性密切相关,进一步促进了蛋白质的消化和吸收。
2.9 分离株发酵小麦胚芽抗氧化能力
通过DPPH、ABTS阳离子、·OH清除实验以及FRAP测试,发现乳酸菌发酵显著提升了SWGP的抗氧化性能(图5)。与未发酵的对照组相比,发酵后的SWGP在DPPH自由基清除能力上显著增强,其中菌株ZJ6最为显著,发酵后的清除率达到了88.68%,接近1 mg/mL 维生素C(91.09%),表明其具有接近合成抗氧化剂的潜力,此结果与WANG等[20]的研究一致。在ABTS阳离子自由基清除实验中,发酵后的SWGP清除率普遍超过90%,其中菌株JX30的清除率最高,达到了93.03%。这一结果与ZOU等[14]关于发酵米酒清除ABTS阳离子自由基的研究趋势一致,进一步证明乳酸菌的代谢产物在自由基清除中具有协同增效作用。·OH清除实验表明,发酵后的SWGP ·OH清除率达到了85%,是未发酵组(42.23%)的2倍,其中菌株LQ35和LH22表现最好。这一提升远高于顾丹丹等[21]报道的羊肚菌发酵小麦时·OH清除率的提升(10.8%),这一差异可能是因为乳酸菌分泌的金属螯合物抑制了·OH的生成。在FRAP实验中,ZJ6菌株还原力达2.212 mmol/L Fe2+,虽低于维生素C(3.5 mmol/L),但显著高于未发酵SWGP。LIU等[22]利用黑曲霉发酵小麦胚芽蛋白时,蛋白酶将小麦胚芽蛋白酶解,使小分子肽暴露更多疏水性氨基酸,更易与不饱和脂肪酸作用,有效清除自由基,这充分说明其在抗氧化方面的显著功效,也证实了小分子肽与高抗氧化活性之间的紧密联系。
3 结论
本研究从腌制蔬菜中筛选出9株高产蛋白酶乳酸菌,经生理生化及分子生物学鉴定为植物乳植杆菌(Lactiplantibacillus plantarum)与肠膜明串珠菌(Leuconostoc mesenteroides),通过对菌株的生长性能与代谢特性进行分析,研究其对SWGP理化性质及抗氧化活性的影响。结果表明,植物乳植杆菌在对数生长期(3~8 h)内,通过较强的生长性能(OD600>2.0)和产酸性能(pH值下降1.35~1.40),可能促使SWGP结构产生变化,并通过增强有机酸生成(总酸增加5.5倍)提高抗氧化能力;而肠膜明串珠菌在衰亡期(22~24 h)内维持稳定的pH值(变化<0.1),为活性物质的积累提供了理想环境。研究发现,菌株LH22在60 ℃高温下存活率达80%,在pH 10.0强碱性环境中存活率超过90%,展现了极端的耐高温及耐碱性能;菌株ZJ6与LH22则分别展现了显著的耐盐性(50 g/L NaCl)和耐胆盐性(4 g/L胆盐浓度),这为固态发酵工艺的优化及肠道靶向递送系统的开发提供了新的思路。通过发酵SWGP,发现菌株ZJ6与JX30的发酵产物能够有效清除DPPH和ABTS阳离子自由基,其清除率分别达到88.68%和93.03%(相当于1 mg/mL的维生素C),且在蛋白质含量上有明显降低,这与JUSTUS等[23]的研究(即蛋白水解度与抗氧化活性呈正相关)相符。本研究通过菌株生长-代谢特性与抗氧化活性的关联分析,为蛋白酶乳酸菌协同增效体系以及乳酸菌功能性食品开发提供了理论依据及数据支持。
[1] OTHMAN M, ARIFF A B, RIOS-SOLIS L, et al.Extractive fermentation of lactic acid in lactic acid bacteria cultivation:A review[J].Frontiers in Microbiology, 2017, 8:2285.
[2] KARAYE G P.Isolation and in vitro screening of lactic acid bacteria from some local brewed drinks, rotten fruits, pig hindgut and their characterization[J].Open Access Journal of Microbiology &Biotechnology, 2020, 5(1):1-11.
[3] KANDEIL M A M, HASSANIN K M A, MOHAMMED E T, et al.Wheat germ and vitamin E decrease BAX/BCL-2 ratio in rat kidney treated with gentamicin[J].Beni-Suef University Journal of Basic and Applied Sciences, 2018, 7(3):257-262.
[4] KHOSROSHAHI E D, RAZAVI S H, KAINI H, et al.Improvement of stability and antioxidant activity of wheat germ by mixed fermentation versus single fermentation[J].Journal of Food Science and Technology, 2022, 59(7):2905-2912.
[5] YU L S, YE G B, QI X T, et al.Purification, characterization and probiotic proliferation effect of exopolysaccharides produced by Lactiplantibacillus plantarum HDC-01 isolated from sauerkraut[J].Frontiers in Microbiology, 2023, 14:1210302.
[6] MA H, WANG L, YU H J, et al.Protease-producing lactic acid bacteria with antibacterial properties and their potential use in soybean meal fermentation[J].Chemical and Biological Technologies in Agriculture, 2022, 9(1):40.
[7] 李斯淼, 陈芳敏, 方丽, 等.一株家蚕肠道分离乳酸菌的鉴定及生物学特性[J].微生物学通报, 2025, 52(2):771-784.LI S M, CHEN F M, FANG L, et al.Identification and biological characterization of a lactic acid bacterial strain isolated from the gut of Bombyx mori[J].Microbiology China, 2025, 52(2):771-784.
[8] DUCHE R T, SINGH A, WANDHARE A G, et al.Antibiotic resistance in potential probiotic lactic acid bacteria of fermented foods and human origin from Nigeria[J].BMC Microbiology, 2023, 23(1):142.
[9] GEORGE P B L, ROSSI F, ST-GERMAIN M W, et al.Antimicrobial resistance in the environment:Towards elucidating the roles of bioaerosols in transmission and detection of antibacterial resistance genes[J].Antibiotics, 2022, 11(7):974.
[10] 周宁, 张建新, 樊明涛, 等.酸奶中保加利亚乳杆菌药物敏感性分析[J].食品科学, 2012, 33(21):202-207.ZHOU N, ZHANG J X, FAN M T, et al.Antibiotic susceptibility of Lactobacillus bulgaricus isolated from yoghurt[J].Food Science, 2012, 33(21):202-207.
[11] ROBICSEK A, STRAHILEVITZ J, SAHM D F, et al.Qnr prevalence in ceftazidime-resistant Enterobacteriaceae isolates from the United States[J].Antimicrobial Agents and Chemotherapy, 2006, 50(8):2872-2874.
[12] LIU F R, CHEN Z X, SHAO J J, et al.Effect of fermentation on the peptide content, phenolics and antioxidant activity of defatted wheat germ[J].Food Bioscience, 2017, 20:141-148.
[13] 陈琳, 黄璐, 于五美, 等.植物乳植杆菌对燕麦发酵过程中的稳定性及挥发性物质影响[J].食品与发酵工业, 2025, 51(16):230-235.CHEN L, HUANG L, YU W M, et al.Effects of Lactiplantibacillus plantarum on stability and volatile substances during oat fermentation[J].Food and Fermentation Industries, 2025, 51(16):230-235.
[14] ZOU J, GE Y N, ZHANG Y, et al.Changes in flavor- and aroma-related fermentation metabolites and antioxidant activity of glutinous rice wine supplemented with Chinese chestnut (Castanea mollissima Blume)[J].Fermentation, 2022, 8(6):266.
[15] 张平, 张鹏飞, 刘斯琪, 等.自然发酵豆酱中明串珠菌的分离鉴定[J].食品科学, 2018, 39(22):110-115.ZHANG P, ZHANG P F, LIU S Q, et al.Isolation and identification of Leuconostoc from traditional fermented soybean paste[J].Food Science, 2018, 39(22):110-115.
[16] ZHANG D L, LIU H, ZHANG Y M, et al.Heat shock protein 60 (HSP60) modulates adiponectin signaling by stabilizing adiponectin receptor[J].Cell Communication and Signaling, 2020, 18(1):60.
[17] ANWAR S, ALI B, SAJID I.Screening of rhizospheric actinomycetes for various in-vitro and in-vivo plant growth promoting (PGP) traits and for agroactive compounds[J].Frontiers in Microbiology, 2016, 7:1334.
[18] OBIOHA P I, ANYOGU A, AWAMARIA B, et al.Antimicrobial resistance of lactic acid bacteria from nono, a naturally fermented milk product[J].Antibiotics, 2023, 12(5):843.
[19] ZHANG H, CHEN Y J, GUO Y F, et al.Label-free quantification proteomics reveals the active peptides from protein degradation during anaerobic fermentation of tea[J].LWT, 2021, 150:111950.
[20] WANG H Y, LI L.Comprehensive evaluation of probiotic property, hypoglycemic ability and antioxidant activity of lactic acid bacteria[J].Foods, 2022, 11(9):1363.
[21] 顾丹丹, 董雪, 张金秀, 等.小麦羊肚菌菌粮制备工艺优化及营养成分、理化性质和抗氧化活性分析[J].食品工业科技, 2025, 46(4):237-245.GU D D, DONG X, ZHANG J X, et al.Optimization of the solid-state fermentation process for Morchella esculenta fermented wheat and analysis of its nutritional components, physicochemical properties and antioxidant activity[J].Science and Technology of Food Industry, 2025, 46(4):237-245.
[22] LIU Y Y, ZHOU Y, ZHU C H, et al.Optimization of fermentation process of wheat germ protein by Aspergillus niger and analysis of antioxidant activity of peptide[J].Fermentation, 2024, 10(3):121.
[23] JUSTUS A, PEREIRA D G, IDA E I, et al.Combined uses of an endo- and exopeptidase in okara improve the hydrolysates via formation of aglycone isoflavones and antioxidant capacity[J].LWT, 2019, 115:108467.